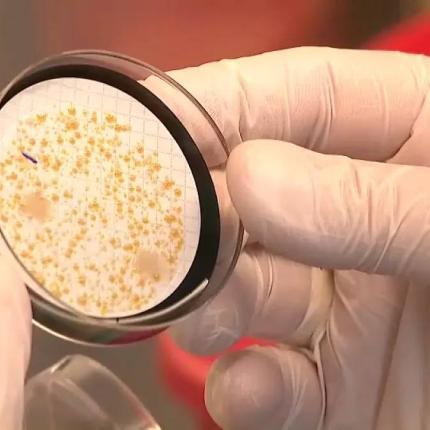
Νόσος των Λεγεωνάριων

Η 90χρονη εμφάνισε συμπτώματα αναπνευστικής δυσανεξίας την Τρίτη και υπέκυψε στα συμπτώματα λίγο μετά την μεταφορά της στο νοσοκομεί
Νεκρή ανασύρθηκε η άτυχη γυναίκα
Μια γυναίκα εντοπίστηκε νεκρή...
Τραγικός ήταν ο επίλογος για την 57χρονη Λαρισαία που το μεσημέρι της Παρασκευής εντοπίστηκε νεκρή στο κέντρο της...
Νεκρή εντοπίστηκε γυναίκα στις Φέρες Αλεξανδρούπολης, το πρωί της Πέμπτης (19/03). Σύμφωνα με την Πυροσβεστική...
Τo ότι προχώρησε σε τέτοιες πράξεις μέρα μεσημέρι ακόμα δεν μπορεί να το χωρέσει ανθρώπου νους
Τραγωδία το βράδυ του Σαββάτου στο Ηράκλειο. Μία 50χρονη γυναίκα βρέθηκε νεκρή, δίπλα στο αυτοκίνητό της στην περιοχή...
Άγνωστοι έσπασαν τάφους...
Η γυναίκα είχε βρεθεί χθες νεκρή μέσα στο σπίτι της...
Τραγική κατάληξη είχε φωτιά...